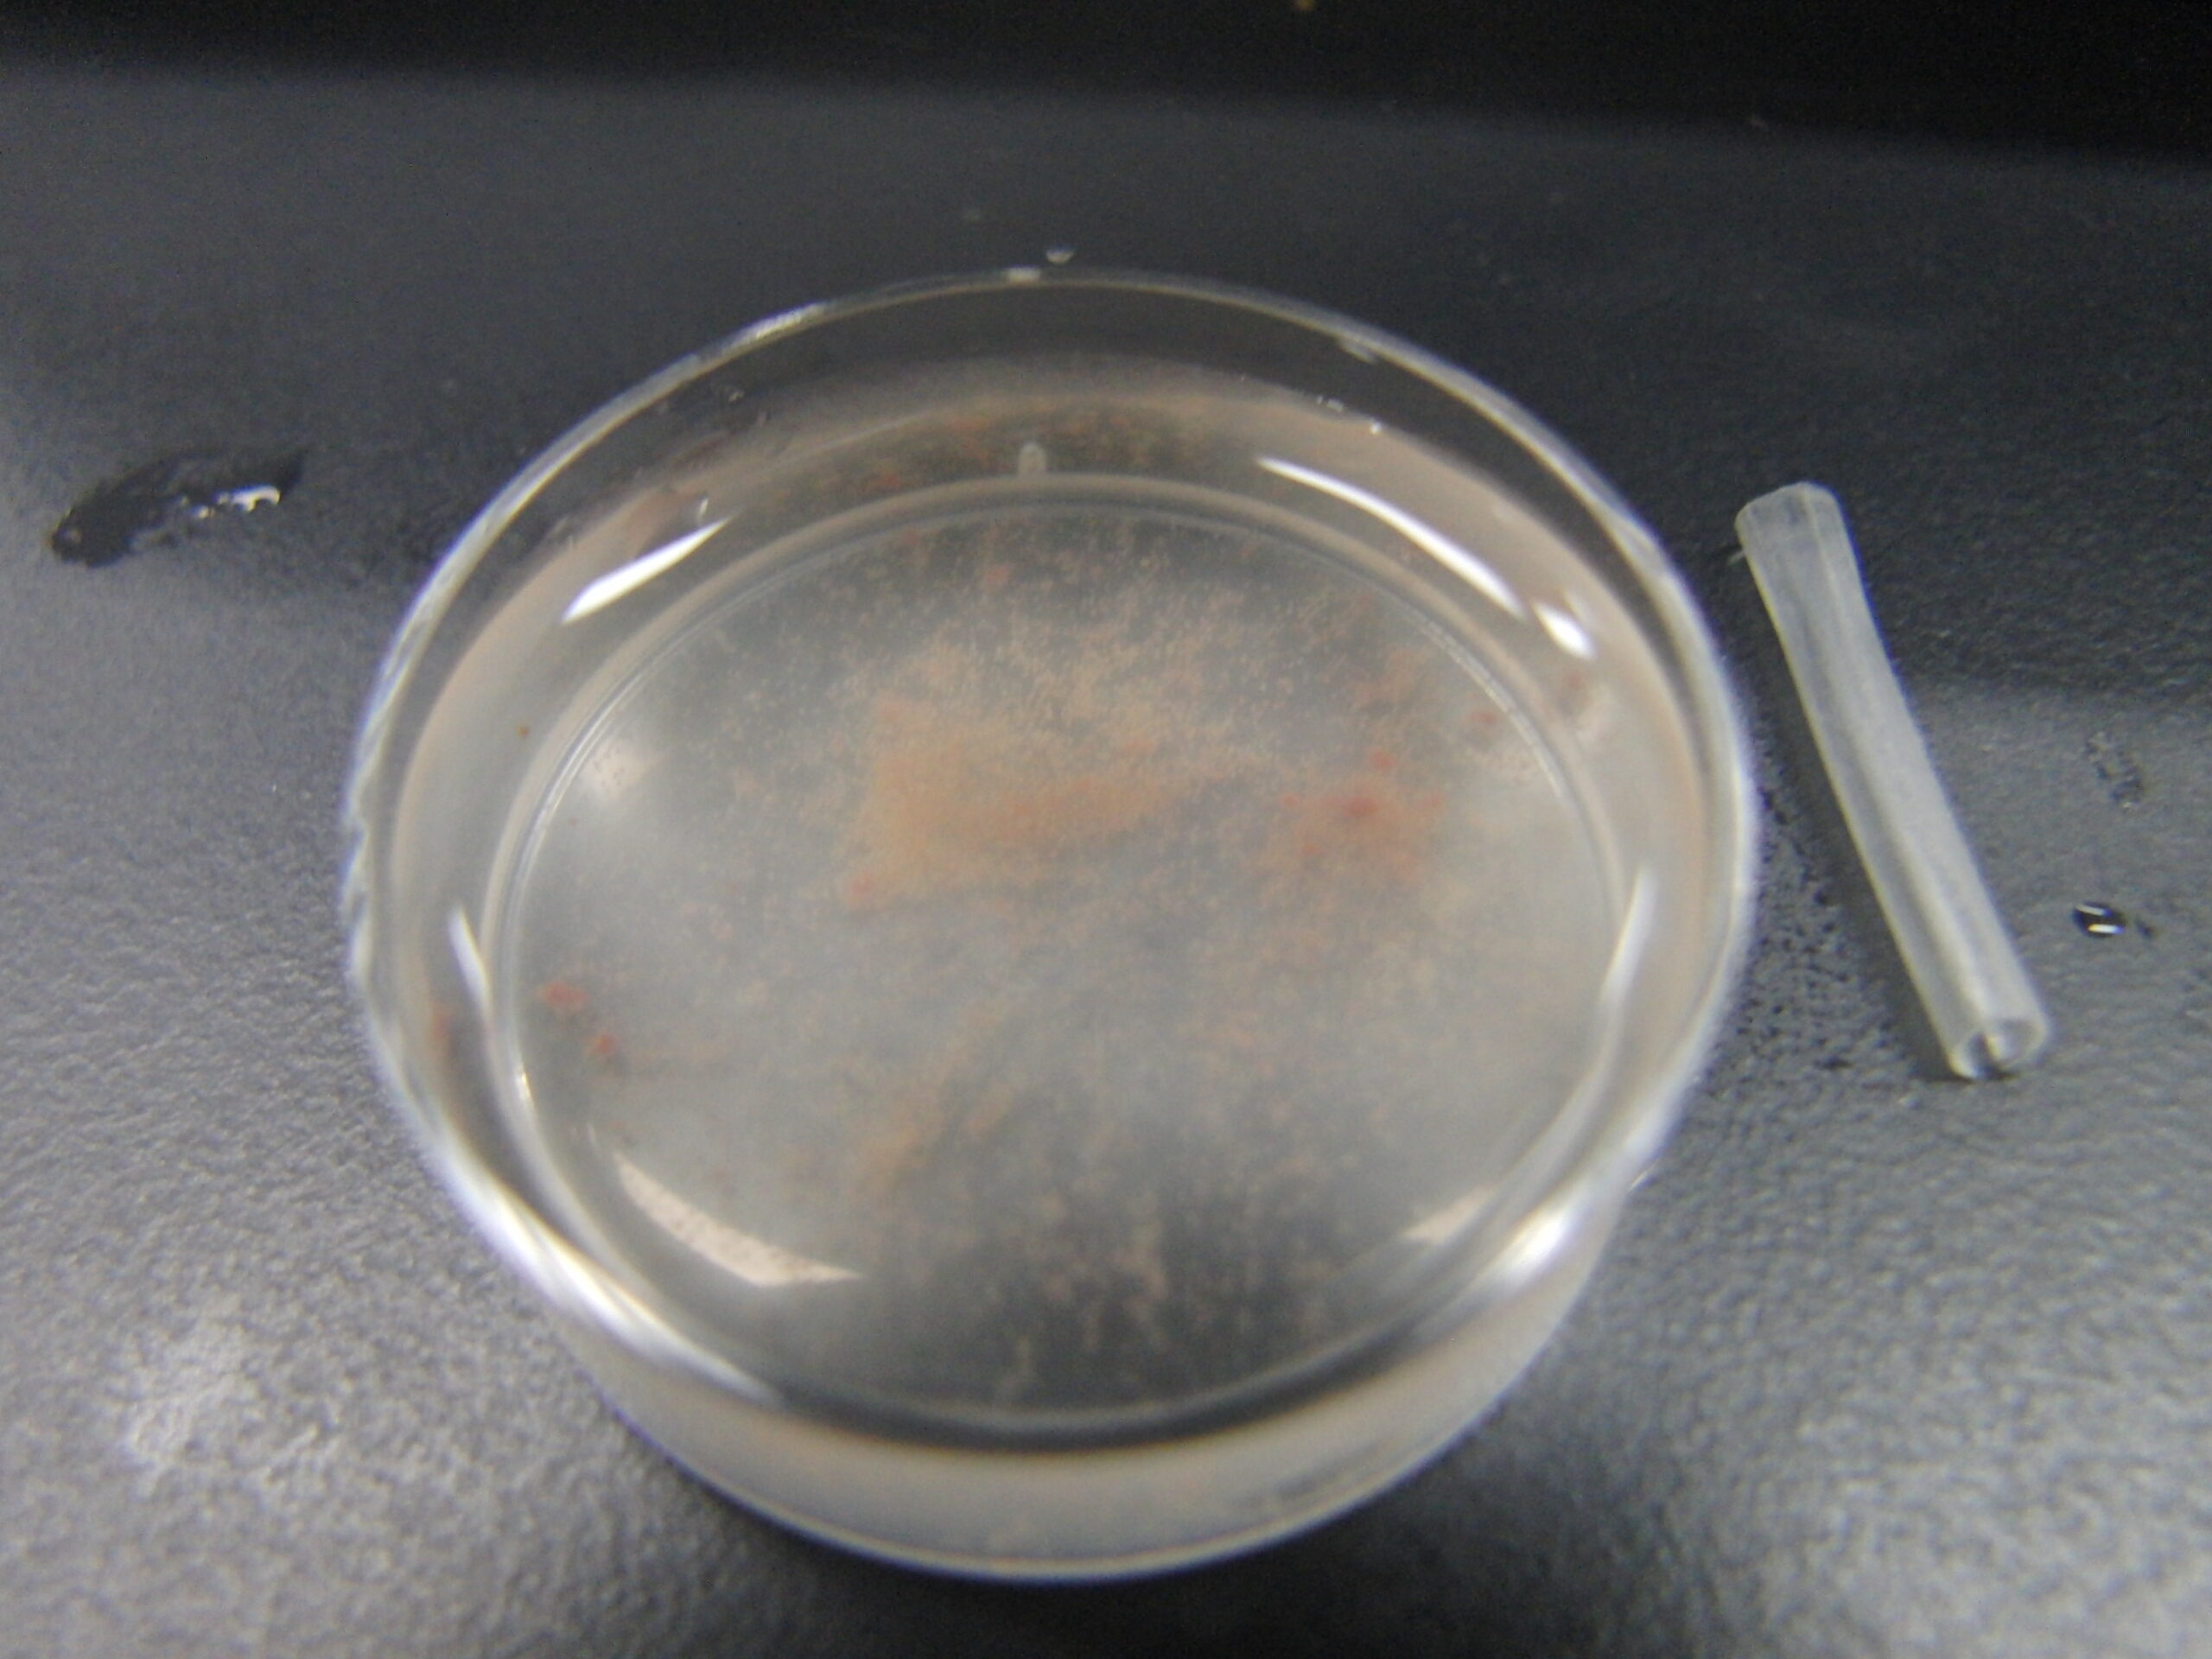

※旧ブログで2014-08-22に更新した記事をこちらに移行しました。
ちなみにもう一つの「ウニ編」はこちら
カサガイ(笠貝)編。
コウダカアオガイ と クサイロアオガイ
クサイロアオガイは、白っぽいのが♂、黒っぽいのが♀

クサイロアオガイ


メスだったので卵をとってみました。
顕微鏡で見ました。減数分裂の第一分裂前期の段階にある未成熟卵(一時卵母細胞)。いびつな形で、周囲は透明な濾胞細胞の層で囲まれています。

おまけにムシロガイという貝の上にタマクラゲのポリプが共生している図(たぶん)


コメント